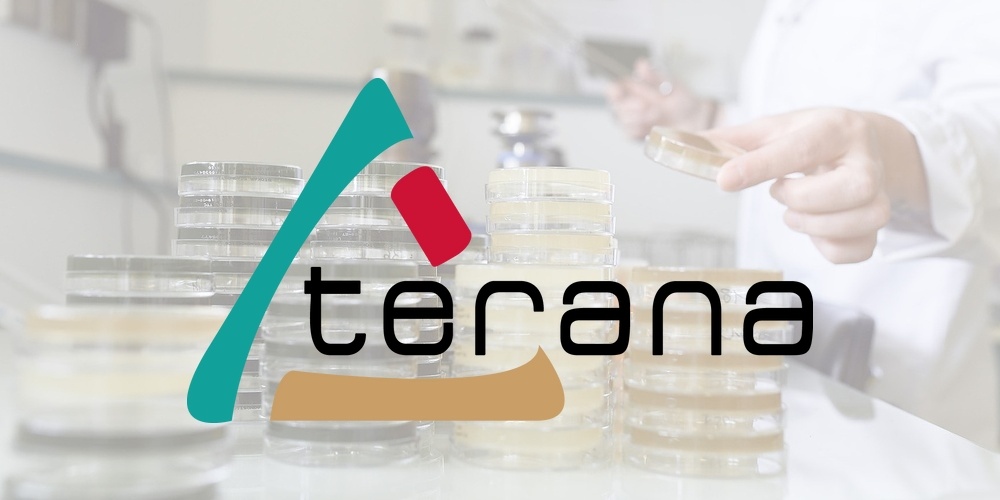
Terana

Emplois actuels liés à Technicien / Technicienne de maintenance industrielle H/F - Montbrison, Auvergne-Rhône-Alpes - SOLYFONTE
-
Technicien de maintenance
il y a 1 semaine
Montbrison, Auvergne-Rhône-Alpes, France Axalta Temps pleinAxalta est restée à l'avant-garde de l'industrie des revêtements en investissant continuellement dans des solutions innovantes. Nous concevons des technologies qui protègent les produits de nos clients - qu'ils luttent contre la chaleur, la lumière, la corrosion, l'abrasion, l'humidité ou les produits chimiques - et ajoutons dimension et beauté avec...
-
Technicien de maintenance
il y a 1 semaine
Montbrison, Auvergne-Rhône-Alpes, France Axalta Temps pleinAxalta est restée à l'avant-garde de l'industrie des revêtements en investissant continuellement dans des solutions innovantes. Nous concevons des technologies qui protègent les produits de nos clients - qu'ils luttent contre la chaleur, la lumière, la corrosion, l'abrasion, l'humidité ou les produits chimiques - et ajoutons dimension et beauté avec...
-
Technicien de maintenance
il y a 3 semaines
Montbrison, Auvergne-Rhône-Alpes, France Axalta Temps pleinAxalta est restée à l'avant-garde de l'industrie des revêtements en investissant continuellement dans des solutions innovantes. Nous concevons des technologies qui protègent les produits de nos clients - qu'ils luttent contre la chaleur, la lumière, la corrosion, l'abrasion, l'humidité ou les produits chimiques - et ajoutons dimension et beauté avec...
-
Technicien de maintenance
il y a 4 heures
Montbrison, Auvergne-Rhône-Alpes, France Axalta Temps pleinAxalta est restée à l'avant-garde de l'industrie des revêtements en investissant continuellement dans des solutions innovantes. Nous concevons des technologies qui protègent les produits de nos clients - qu'ils luttent contre la chaleur, la lumière, la corrosion, l'abrasion, l'humidité ou les produits chimiques - et ajoutons dimension et beauté avec...
-

Technicien de laboratoire en hygiène alimentaire H/F
il y a 3 semaines
Montbrison, Auvergne-Rhône-Alpes, France TERANA Temps pleinNous recrutons un(e) technicien(ne) de laboratoire en hygiène alimentaire pour rejoindre nos équipes au sein de TERANA.TERANA, C'EST QUOI ?Nous sommes un Groupement d'Intérêt Public (GIP) créé en 2016 qui regroupe 9 départements : le Cantal, le Cher, la Drôme, l'Indre, la Loire, la Haute-Loire, la Nièvre, le Puy-de-Dôme et le Rhône. Force de nos...
-

Responsable bureau d'études électriques F/H
il y a 3 jours
Montbrison, Auvergne-Rhône-Alpes, France Eiffage Temps pleinEiffage Énergie Systèmes conçoit, réalise, exploite et maintient des systèmes et équipements en génies électrique, industriel, climatique et énergétique dans le respect des Hommes et de l'environnement.Eiffage Énergie Systèmes propose une offre sur mesure pour les marchés de l'industrie, des infrastructures et réseaux, des villes et...
-

Technicien de laboratoire en hygiène alimentaire H/F
il y a 3 jours
Montbrison, Auvergne-Rhône-Alpes, France Terana Temps pleinNous recrutons un(e) technicien(ne) de laboratoire en hygiène alimentaire pour rejoindre nos équipes au sein de TERANA.TERANA, C'EST QUOI ? Nous sommes un Groupement d’Intérêt Public (GIP) créé en 2016 qui regroupe 9 départements : le Cantal, le Cher, la Drôme, l'Indre, la Loire, la Haute-Loire, la Nièvre, le Puy-de-Dôme et le Rhône. Force de...
-
Technicien de laboratoire en hygiène alimentaire H/F
il y a 24 heures
Montbrison, Auvergne-Rhône-Alpes, France Terana Temps pleinNous recrutons un(e) technicien(ne) de laboratoire en hygiène alimentaire pour rejoindre nos équipes au sein de TERANA.TERANA, C'EST QUOI ? Nous sommes un Groupement d’Intérêt Public (GIP) créé en 2016 qui regroupe 9 départements : le Cantal, le Cher, la Drôme, l'Indre, la Loire, la Haute-Loire, la Nièvre, le Puy-de-Dôme et le Rhône. Force de...
-

Chef de chantier process industriels
il y a 3 semaines
Montbrison, Auvergne-Rhône-Alpes, France Eiffage Énergie Systèmes Temps pleinPour Eiffage Énergie Systèmes, notre marqueClemessyest spécialisée en conception, réalisation, exploitation et maintenance des systèmes électriques sur sites industriels & Automatisme et Informatique industrielle. Notre agence située àMontbrison (42)recrute dans le cadre de son développement un(e) :Chef de chantier F/HProcess Industriels et...
-

Informaticien industriel F/H
il y a 2 jours
Montbrison, Auvergne-Rhône-Alpes, France Eiffage Temps pleinEiffage Énergie Systèmes conçoit, réalise, exploite et maintient des systèmes et équipements en génies électrique, industriel, climatique et énergétique dans le respect des Hommes et de l'environnement.Eiffage Énergie Systèmes propose une offre sur mesure pour les marchés de l'industrie, des infrastructures et réseaux, des villes et...

Technicien / Technicienne de maintenance industrielle H/F
il y a 3 jours
À propos de nous :
Solyfonte est une fonderie d'art située à Montbrison, au cœur de la Loire.
Reconnue Entreprise du Patrimoine Vivant (EPV) par l'État français et labellisée Artisans de France, notre société se distingue par son savoir-faire artisanal d'exception.
Solyfonte travaille aussi bien sur des pièces uniques que sur des petites et grandes séries, dans un flux de production continu.
Avec 170 collaborateurs, notre entreprise connaît une croissance constante depuis plusieurs années.
Dans le cadre de notre développement, nous créons un nouveau poste de Technicien de maintenance h/f afin de renforcer notre équipe.
Objectifs :
Le/la technicien(ne) de maintenance industrielle assure le bon fonctionnement, la disponibilité et la conformité des équipements industriels et des infrastructures du site.
Il/elle intervient sur les opérations de maintenance corrective, préventive, prédictive et réglementaire, tout en garantissant la sécurité des personnes, des installations et le respect des exigences QHSE.
Responsabilités :
Maintenance corrective / curative :
Diagnostiquer les pannes mécaniques, électriques, pneumatiques et hydrauliques
Réaliser les dépannages et réparations dans le respect des règles de sécurité
Analyser les causes des dysfonctionnements afin d'éviter leur réapparition
Maintenance préventive :
Réaliser et suivre le plan de maintenance préventive
Effectuer les contrôles périodiques des équipements
Réaliser les opérations de graissage, réglage, nettoyage et remplacement de pièces
Renseigner les interventions dans les outils de suivi
Maintenance prédictive :
Surveiller les paramètres de fonctionnement des équipements
Détecter les dérives et anticiper les pannes
Proposer des solutions techniques adaptées
Maintenance réglementaire :
Garantir la conformité des installations (électricité, levage, sécurité machines, etc.)
Suivre et préparer les contrôles réglementaires obligatoires
Mettre en œuvre les actions correctives suite aux rapports de contrôle
Maintenance améliorative :
Participer à la fiabilisation des équipements
Proposer et mettre en œuvre des améliorations techniques
Contribuer à l'optimisation des performances des installations
Gestion et coordination :
Gérer les pièces de rechange (stock, commandes, suivi)
Suivre et coordonner les interventions des prestataires externes
Superviser les référents électriques du site
Former et sensibiliser les collaborateurs aux bonnes pratiques de maintenance et de sécurité
Assurer la communication avec les sociétés externes et les services internes
Conditions et avantages :
- CDI 39h
- Une rémunération, en fonction de votre profil et de votre expérience
- Prime semestrielle
- Carte restaurant (6€/jour prise en charge 50%)
- Comité d'entreprise
- Accord d'intéressement
- Salle de sport entreprise
- Horaires au choix : 8h00 – 16h30 ou 7h30 – 16H00 vendredi 15h00 ou 15h30
Comment postuler ?
Envoyez-nous votre CV à l'adresse suivante :
Ou postulez directement via la plateforme directement.
Rejoignez notre équipe

